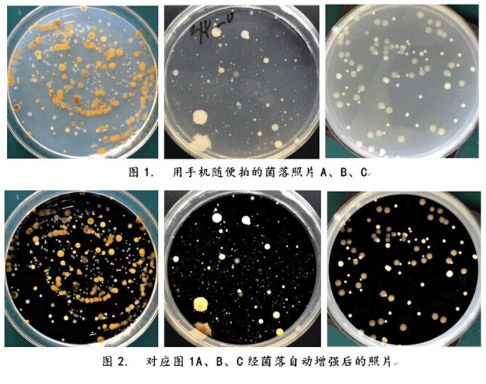

谨防空调综合症 加护灵成居家必备健康产品
现已入秋了,但部分地区的气温依然有30℃以上,绝大多数人家中的空调依旧保持着常开状态。虽说空调为我们的生活带来了很多凉爽与舒适,但也在我们的日常生活中埋下了一些健康隐患。近几年,越来越多人会出现头晕、鼻塞流涕、皮肤过敏等症状,甚至还有人出现呼吸道问题,这些都与长期使用空调不无关系。
众所周知,为了防止冷气散掉,在使用空调时,我们通常会将门窗关闭。长此以往,人、房间与空调之间形成了一个相对封闭的循环系统,在这个循环系统中,细菌、病毒、霉菌等微生物得以大量繁殖,甚至某些微生物还会借助空调系统的出风口传播,成为呼吸道疾病的污染源。
据《中国预防医学杂志》记载,中国疾病预防控制中心与深圳市疾病预防控制中心,曾经进行过一次针对家用空调微生物污染问题的流行病学调查,以深圳和北京两地为样品选择,对居民家用空调微生物菌落进行了调查。最终结果显示所测试的多个样本环境中空调微生物菌落均严重超标,最高菌落数甚至达到1024 cfu/cm2,远高于100 cfu/cm2的国家标准。长期使用空调的危害由此可想而知。
(图片来源网络)
面对日益严重的“空调危害”,通常我们会强调保持通风、定期清理,但这还远远不够,因为在流动的空气中仍然存在着看不见的病菌。如何才能彻底清除它们?这是摆在人类面前的共同难题。
有问题,就有答案。来自日本的加护灵跳出了传统的除菌方式,给出了全新的解决方案——空间除菌,全天候的空间守护,从根本上解决了空调危害。

加护灵 360度除菌更彻底
在我们日常生活中,飘浮着各式各样的有害物质,平均每1g灰尘里就有大约800万个细菌。不敢想象,我们每天会吸入多少灰尘和细菌。目前市面上的除菌产品,大部分主要还是以局部除菌为主,完全达不到对室内空气环境的彻底防护。
面对此类问题,加护灵创立了一个全新的除菌方式,通过主动释放二氧化氯气体,作用于空气和物表,去除病毒和细菌,对室内环境做了一个整体的防护,就算在使用空调期间也并不冲突,可以帮助减少封闭环境中的细菌滋生机率。就像是给整个房间创造了一个巨大的过滤网,筛掉各类细菌、尘螨过敏原、有害病毒等。
日本实验室曾就加护灵产品进行了实验,在某小学的教室内摆放了一些加护灵,观察1~3个月的学生生病缺席情况。最终结果显示摆放加护灵的教室比没有摆放加护灵的学生缺席率要低得多,更不容易生病。

加护灵 专利释缓技术更安全
二氧化氯是世界卫生组织认证的第四代绿色消毒成分,常用于医学、食品、科学等领域,是少有的对人体无害的A1级安全消毒剂。目前市面上也有很多以二氧化氯成分为主的除菌产品,但效果都参差不齐,而且挥发释放的浓度难以控制。当空调开放、环境封闭的情况下,浓度难以控制的问题就变得更加严重。
当然,这一问题也是加护灵一开始就非常关注的难题,为了能够达到更加安全的标准,团队尝试多种方式,终于研究出一种独有的释缓技术,将加护灵的二氧化氯气体可以稳定地控制在0.01ppm,远低于美国饮用水0.8ppm的浓度标准,更安全,在开空调封闭的情况下依然可以使用。
加护灵就浓度问题也进行了相应的小白鼠试验,测试时间长达六个月,结果显示在0.1ppm以及0.05ppm的浓度下,小白鼠的身体状况都能保持正常。

2014年3月,日本二氧化氯工业协会更是确定0.01ppm作为二氧化氯气体在室内释放浓度的安全标准。
加护灵 无需插电更便捷
除此之外,加护灵还有一个非常大的优势,就是无需插电,随拿随用!日常家庭进行除菌工作时,常常会花费一整天的时间来清扫全屋,喷洒相关除菌产品,不仅费时费力,还无法保证除菌效果。而加护灵就不一样了,它只需要轻轻放置就可以进行除菌,十分方便。对家里有老人、小孩或者行动不便的人来说,也是一个非常好的家用除菌选择,轻松做到“三省”:省钱、省时、省力!

据了解,加护灵自面世以来,连续多年日本市占率第一,帮助超6成以上的日本家庭创造健康的呼吸环境,远离空调综合症。现今,加护灵也已经进入中国市场,帮助中国家庭创造更好的生活环境,打造全新的健康呼吸空间。
相关知识
谨防夏季“空调肺”,WD-40空调消毒剂来了
海尔洗空气空调产品冬季走俏,带来健康居家新体验!
沁园小净灵:防疫期间的健康饮水好选择
轻松应对换季,松下F1系列空调守护家庭呼吸健康
沁园小净灵,助益健康水生活
空调推荐品牌再成热点,海尔空调引发关注
居家空气憋闷怎么办?帮你推荐这几款海尔健康空调
TCL空调重磅发布2021全新智慧新风空调
灵灵狗是哪里的智能门锁品牌?
居家防疫健康从莱卡净水开始:意大利莱卡LAICA净饮机
推荐资讯
- 1顾家家居37周年,家居电商的 72486
- 2小米电视卸载自带应用教程!手 71584
- 3灯塔组设计批评:光的背面 49430
- 4新中式设计,灰色调的空间,简 46504
- 5地暖机和壁挂炉有啥区别?装地 15256
- 6宝子们,看看这个意式极简风设 15240
- 7恭祝泰安文华里【武府】开工大 15212
- 8武汉新房甲醛治理,这些门道要 15145
- 9龙湖集团与蚂蚁集团达成战略合 13746
- 10大门向东属于什么宅?居家风水 13592